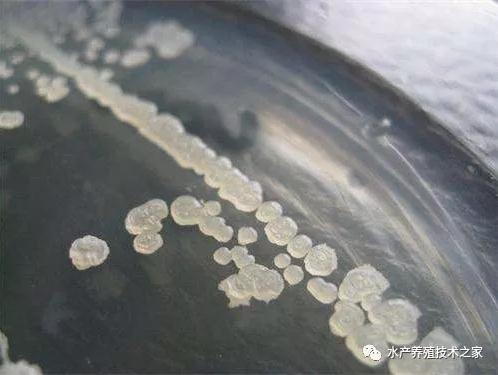
QQ浏览器截�?0190909180524.jpg QQ浏览器截�?0190909180524.jpg
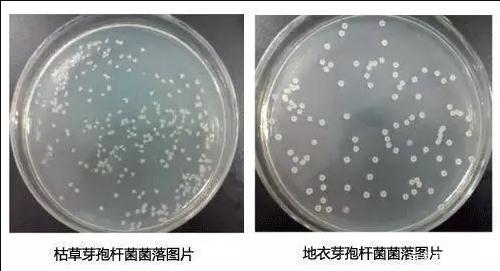
QQ浏览器截�?0190909180605.jpg QQ浏览器截�?0190909180605.jpg

主要的影响因素
一、溶解氧
1、水体溶解氧的高低,会影响到好氧菌生长速率和氧化分解污染物的效率。
目前芽孢类微生物制剂为好氧菌(或兼性),使用含有这类活菌的产品,一定要保持水体足够的溶氧,才能维持细菌快速繁殖和对污染物的有效分解。
2、池塘底部低溶氧会影响生物底改的使用效果。
生物底改主要是要使用芽孢类微生态制剂。芽孢类微生态制剂改底需要大量氧气。尤其是养殖的中、后期,池塘底部是污染最严重的区域,底部积累的耗氧因子往往会使底部溶解氧消耗殆尽,这些细菌在缺氧的环境中生长繁殖并不理想。虽然直接到了底部,但大部分细菌休眠或没有繁殖,甚至死亡。
有些生物底改剂推荐配合缓释型增氧片使用,也是通过增加溶氧来促进生物底改的效果。

目前市场上增氧产品种类繁多。传统的增氧产品受技术和配方制约,一般为3-8小时集中放氧。该类集中放氧的产品短时间内迅速放氧,氧气容易快速溢出水体,池塘存留效果差,且对养殖动物刺激性较大。同时使用成本高,并需要人工时时关注增氧情况。最新的技术是采用先进的缓释技术和特殊配方,使氧气可以在池底缓慢释放,增氧效果长达30个小时以上。该类增氧产品成本低,放氧时间长久且持续,省时省事又省力。
二、pH值
在藻类光合作用下,低碱度水体相对于高的水体pH值波动大。芽孢杆菌都有一个最佳pH值范围,过大的pH值波动会影响芽孢杆菌的效果。芽孢类微生态制剂在微碱性反应的环境中良好地生长,对pH值的变化反应明显。
池塘底部发酵产生的有机酸积累,碱度太低,会使底部pH值很低,会严重影响芽孢类微生物制剂对池塘底部的改良效果。
三、天气状况
大多数芽孢杆菌在20~3O℃ 内有比较好的活性,水温10℃以下时活性明显降低。
在使用芽孢类微生态制剂时要注意水温对产品效果的影响。天气好坏会影响到藻类的繁殖和水色变化,对于以水色变化与否来检验产品的养殖。
最好在晴天上午使用,同时开增氧机增氧,选择合适的时间使用会有更好的效果。
四、营养缺乏或过多
芽孢类微生态制剂进入水体后繁殖速度与水体的营养水平有很大的关系。一般认为细菌生长对水体C、N、P的利用率100:5:1。
如果水体太瘦,或营养成分单一或失衡,有些异养菌为主的活菌制剂不会大量繁殖,使用活菌几乎无效,此时应向水体中适当补充缺乏的营养才能达到更好的效果。
最后,适量的有害物质如氨氮,亚硝酸盐,硫化氢或有机物的存在是必要的,因为细菌只有以此为基础才能获得能量生存繁殖,但过量了也会对微生物产生毒害作用。
因此,我们在使用芽孢类微生物制剂时要充分考虑这些因素对产品使用效果的影响。
上一篇:虾塘重金属浓度高用什么解
下一篇:改底到底该怎么改